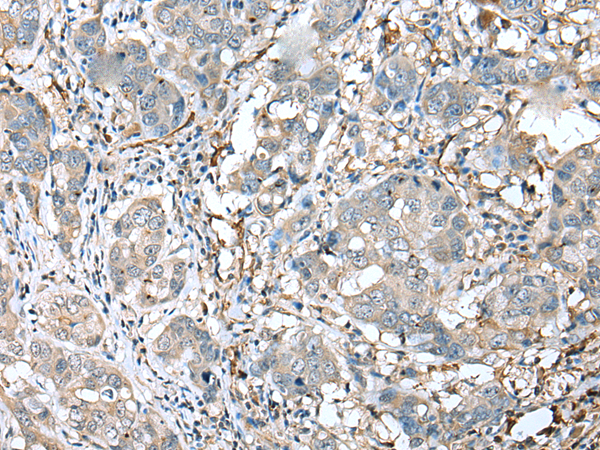

|
Background: |
This gene encodes a receptor belonging to the Ig superfamily that is expressed on myeloid cells. This protein amplifies neutrophil and monocyte-mediated inflammatory responses triggered by bacterial and fungal infections by stimulating release of pro-inflammatory chemokines and cytokines, as well as increased surface expression of cell activation markers. Alternatively spliced transcript variants encoding different isoforms have been noted for this gene. |
|
Applications: |
ELISA, WB, IHC |
|
Name of antibody: |
TREM1 |
|
Immunogen: |
Full length fusion protein |
|
Full name: |
triggering receptor expressed on myeloid cells 1 |
|
Synonyms: |
CD354; TREM-1 |
|
SwissProt: |
Q9NP99 |
|
ELISA Recommended dilution: |
2000-5000 |
|
IHC positive control: |
Human breast cancer and Human brain |
|
IHC Recommend dilution: |
25-100 |
|
WB Predicted band size: |
26 kDa |
|
WB Positive control: |
Hepg2 and 293T cell |
|
WB Recommended dilution: |
200-1000 |
購物車
幫助
021-54845833/15800441009
